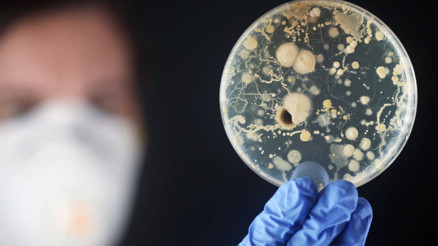
ABDde beyin yiyen amip vakası görüldü

Yapay Göl
yapay göl’a ait tüm site haberleri

Boşandıktan sonra burayı kendine yuva yapmıştı... Kızlarını burada büyüttü, şimdi sıra torunlarında
Herkes onu aşkların ve evliliklerin kısa sürdüğü gösteri dünyasının en vefalı isimlerinden biri olarak tanıyor. Bu durum hiç de haksız değil aslına bakılırsa... Çünkü bırakın ünlüler dünyasını sıradan çiftler arasında bile boşanıp başkasıyla evlenen kocasını tam da evlilik yeminindeki gibi "iyi günde, kötü günde" terk etmeyene rastlamak gerçekten zor.
#Demi Moore
Hayran hayran birbirlerine baktılar ama beş çocukla bir eve sığamadılar
Geçen yılın en çok ilgi çeken olaylarından biriydi Jennifer Lopez ile Ben Affleck'in tam 20 yıl aradan sonra muratlarına ermesi. Önce sürpriz Las Vegas düğünü, ardından Ben Affleck'in lüks malikanesinde yapılan ve günlerce süren gösterişli düğün derken, bir zamanlar nişanlanıp ayrılan çift bu kez gerçekten bir aile oldular.
#Jennifer Lopez
Bu gizem neredeyse 40 yıldır çözülemiyor! 15 yaşındaki Emanuela Ornaldi'ye ne oldu?
Henüz 15 yaşındaydı. Bir gün çok sevdiği flüt dersine gitmek için evden çıktı, bir daha da kendisinden haber alınamadı. Ailesi onu bulmak için var gücüyle savaştı. Akıbetine ilişkin iddiaların ucu 1983'ten bugüne kadar uzandı. Flaş bir gelişme Emanuela Orlandi'yi 39 yıl sonra yeniden manşetlere taşıdı...
#Emanuela Orlandi
Bir kış masalı: Karın en çok yakıştığı göller | 10 ŞEHİR 15 ÖNERİ
Büyük şehirlerin trafiği, stresi ve en önemlisi bütün bir hafta yorucu geçen iş koşuşturmasından sıkılanlar, hafta sonlarını iple çekiyor. Biz de uzmanlarımıza kışla birlikte güzel manzaralara bürünen, doğanın içinde ailece vakit geçirilecek en güzel gölleri sorduk. 10 şehirden keşfedilmeyi bekleyen 15 gölü önerdiler.
#Tatil
Bodrum susuz mu kalacak? Tehlike kapıda...
Rize’den sonra Türkiye'nin en fazla yağış alan ikinci şehri olan Muğla, son dönemde kuraklık ve su kıtlığıyla savaşıyor. Şehirde 2017 yılında 34, 2020 yılında 46, 2021 yılında ise 88 olmak üzere toplam 168 kuyu tamamen kurudu. Özellikle şehrin en popüler adresi olan Bodrum, bu durumdan en ağır yara alan yer. Bodrum’un içme suyunu karşılayan iki barajdan biri kurudu diğeri ise alarm veriyor. Peki Türkiye’nin incisi Bodrum, artık susuz mu kalacak? Uzmanlar hurriyet.com.tr'ye anlattı.
#Kuraklık
Hollywood'un en zengin aktörü Dwayne Johnson havuzlu çiftlik evini zararına satıyor
Geçen yıl 87.5 milyon dolar ile en çok kazanan erkek oyuncu unvanını eline geçiren Dwayne Johnson ya da namı diğer Rock, geniş bir arazi üzerine inşa edilmiş olan havuzlu çiftlik evini satışa çıkardı. Üstelik de satın aldığına oranla hatırı sayılır bir indirimle.
#Dwayne Johnson
Beyin yiyen amip ile ilgili tüm ayrıntılar! Beyin yiyen amip nedir?
Beyin yiyen amip ile ilgili araştırmalar hızlandı. ABD'nin Florida eyaletinde, bir "beyin yiyen amip" vakasına rastlandı. Bu vakanın ardından vatandaşlar beyin yiyen amip nedir sorusunun yanıtını araştırmaya başladılar. İşte beyinde enfeksiyona yol açan ve vakaların genellikle ölümü ile sonuçlanan naegleria fowler hastalığı ile ilgili bilgiler…
#Beyin Yiyen Amip
Dipsiz Göl nerede? Hangi ilin sınırları içerisinde?
Dipsiz Göl'de define var iddiaları 12 bin yıllık tarihi yok etti. Göl, iddiaya göre, bölgede bir dönem kalan Roma İmparatorluğu'nun Anadolu'daki 4 büyük lejyonu arasında gösterilen, 15'inci Apollinaris lejyonunun var olduğuna inanılan hazinesin nedeniyle kurutuldu. Peki, Dipsiz Göl nerede?
#Dipsiz Göl
Prof. Dr. Bektaş: Dipsiz Göl su tutar mı tutmaz mı tamamen şans
JEOLOJİ mühendisi Prof. Dr. Osman Bektaş, Gümüşhane'nin Taşköprü Yaylası'nda yasal izinle yapılan define kazısı çalışmasında toprak doldurulup, yok edilen Dipsiz Göl'ün eski haline dönüştürülmesi çalışmalarını değerlendirdi. Gölün talana uğradığını belirten Bektaş, "Özellikleri artık kayboldu. Bundan sonra orada yapılacak göl, doğal değil, yapay göl olacaktır. 'Dipsiz Göl, su tutar mı, tutmaz mı?' sorusu ise tamamen şans" dedi.
#Prof. Dr. Osman Bektaş
Kafkaslar’ın Paris’i: Bakü
Bir ülke hayal edin. Sizin filmlerinizi sizden daha çok izleyen. Milli maçlarınızı sizden daha yakından takip eden. Dış siyasetinizi sizden daha iyi bilen. Şehit verdiğinizde sizden daha çok üzülen. Tek davetinizle gözünü kırpmadan peşinizden gelen. Güzel olurdu değil mi? Peki ya gerçekten böyle bir ülke varsa? O zaman Azerbaycan’a hoşgeldiniz. Size bu güzel ülkenin güzel şehri Bakü’den bahsedeceğim…
#Bakü
Urartuların baraj gölünde yüzüp kanoyla gezdiler
Van Gölü Aktivistleri Derneği kentin sahip olduğu turizm potansiyeline dikkat çekmek ve farkındalık oluşturmak amacıyla Keşiş Gölü'ne gezi düzenledi. 50 kişilik bir ekiple Keşiş Gölü'ne gelen aktivistler, yamaçlarında halen karın bulunduğu Erek Dağı eteklerindeki gölde kanolarla gezinti yapıp, yüzmenin keyfini çıkardı.
#Van Gölü
Türkiye’nin en büyük yapay baraj gölünün adı nedir? (Fırat Nehri üzerinde kurulu)
Güneydoğu Anadolu Projesi kapsamında hayata geçirilen ülkemizin yüz ölçümü açısından en büyük yapay baraj gölü Atatürk Barajı’dır. Baraj, Adıyaman ve Şanlıurfa illeri arasında, Fırat Nehri üzerinde kurulu olup, enerji ve sulama amaçlı kullanılmaktadır. İşte, Atatürk Barajı hakkında detaylı bilgi…
#Türkiye’Nin En Büyük Yapay Baraj Gölünün Adı
Apple Park’ın son hali havadan görüntülendi!
Apple’ın 2013 yılında Steve Jobs’un planlarıyla temel attığı Apple Park’ın inşaat çalışmaları devam ediyor. Geçtiğimiz Eylül ayında, inşaat çalışmasının devam etmesine rağmen Apple Park’ın Steve Jobs Amfi salonunda gerçekleşen iPhone lansmanında basın mensuplarına kapılar açılmıştı. Son olarak Apple Park drone pilotu Matthew Roberts tarafından bir kez daha görüntülendi.
#Apple Park